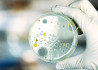
085 Mikrobiologiniai paselio tyrimai 784x480px

Laboratoriniai tyrimai
Hila laboratorijose atliekami skirtingų rūšių laboratoriniai tyrimai vaikams ir suaugusiems – nuo įprastinių kraujo, vitaminų, mikroelementų, Covid-19 tyrimai, širdies, kraujagyslių tyrimai iki sudėtingiausių vėžio žymenų ir molekulinės diagnostikos.
Hila dirba ilgametę patirtį turintys laboratorinės medicinos gydytojai, patologai, medicinos genetikai, naudojama patikimų gamintojų laboratorinė įranga ir reagentai.
Kviečiame palikti savo atsiliepimą apie suteiktą paslaugą arba laboratorinius tyrimus
Mums labai svarbi Jūsų nuomonė apie suteiktas paslaugas. Stengiamės nuolat gerinti jų kokybę ir pacientų aptarnavimo kultūrą.
Visi tinklalapyje pateikti atsiliepimai yra tikri. Atsiliepimus pateikusių pacientų, klientų, lankytojų vardai ir pavardės Hila yra žinomi, tačiau, vykdant galiojančių įstatymų reikalavimus, atsiliepimai yra nuasmeninti.
Kaip atliekami ir kada reikalingi laboratoriniai tyrimai?
Laboratoriniai tyrimai atliekami procedūriniame kabinete, įprastai užtrunka vos keletą minučių. Po kraujo tyrimo iš venos rekomenduojame prispausti dūrio vietą savo pirštu ir palaikyti bent 5 min., kad nesusidarytų mėlynė.
Net 70 proc. klinikinių sprendimų nustatant diagnozę yra priimami remiantis laboratorinių tyrimų rezultatais.
Hila Laboratorinės diagnostikos centre veikia moderniausia laboratorinės analizės sistema Baltijos šalyse, kad gautumėte visus atsakymus apie savo sveikatą.
- Dar tiksliau – visiškai automatizuota analizės sistema
- Dar patikimiau – naujos kartos aplinkos veiksniams atsparūs reagentai
- Išsami diagnostika vos iš kelių mililitrų kraujo
- Pagrindinių tyrimų rezultatai – per kelias valandas*
- Pažangūs aplinkai draugiškesni sprendimai.
Išsamiems tyrimams pakaks vos vieno dūrio – paimtą kraujo mėginį saugome iki 7 dienų, todėl nebereikia duoti daugiau kraujo papildomiems tyrimams atlikti.
Užtikriname jūsų konfidencialumą – jums pageidaujant tyrimus mūsų Laboratorinės diagnostikos centre galite atlikti anonimiškai.
Kaip pasiruošti laboratoriniams tyrimams?
Laboratorinių tyrimų rezultatai bus tikslesni jei atsižvelgsite į savo gydytojo rekomendacijas, kaip pasiruošti konkrečiam tyrimui.
Įprastai rekomenduojama 10-16 val. iki tyrimo nevalgyti, negerti saldžių skysčių, nevartoti alkoholio, narkotikų, bent 15 min iki laboratorinio tyrimo – nerūkyti.
Laboratorinių tyrimų rezultatams įtakos turi:
- Amžius
- Rasė
- Nėštumas
- Mityba
- Alkoholis
- Narkotikai
- Rūkymas
- Kofeinas
- Aukštis, kuriame esate
- Cirkadinis ritmas
- Sezoniškumas
- Fizinis krūvis
- Vartojami vaistai
Dauguma tyrimų galite atlikti be registracijos, tiesiog atvykite ir kreipkitės į registratūrą!
Kaip yra vertinami laboratorinių tyrimų rezultatai?
Pagrindinių tyrimų rezultatai pateikiami per 1-2 valandas, kiti – per 1 darbo dieną, išskyrus atvejus, kai dėl tyrimo specifikos, pavyzdžiui, pasėlio auginimo, rezultatai negali būti pateikti greičiau.
Pacientui pageidaujant tyrimų rezultatai gali būti siunčiami el. paštu ir pateikiami e-sveikata sistemoje.
Kai kurių tyrimų rezultatai, dėl techninių apribojimų, negali būti siunčiami el. paštu. Juos prašome atsiimti Hila registratūroje, pateikus asmens tapatybę įrodantį dokumentą.
Laboratorinių tyrimų normos skirtingose laboratorijose gali skirtis, todėl jei atliekate tyrimus, kurių rodiklius norite stebėti nuolat, pvz. vitamino D, cholesterolio, gliukozės kiekio kraujyje, skydliaukės ar kt. tyrimus, rekomenduojame juos atlikti toje pačioje laboratorijoje.
Laboratoriniai tyrimai Vilniuje – nuo šiol ir mūsų naujajame Šeimos medicinos centre!
Šiame centre gydytojai šeimos gydytojas rūpinasi, kad būtumėte sveiki, o susirgus padeda pasveikti:
- Kiekvienam pacientui skiriame daugiau laiko nei įprastai kitose šeimos klinikose:
- rezervuojame dvigubą konsultacijos laiką pirmajam vizitui (30–60 min.);
- konsultacijai skiriame vidutiniškai 20–30 min.
- paskambinus patarsime, ką daryti, kol lauksite vizito. Šeimos gydytojas Jus priims per 1–3 dienas;
- Hila atliktus tyrimus šeimos gydytojas pakomentuos be papildomo mokesčio.
Mūsų Šeimos medicinos centre šeimos gydytojas įprastai diagnozuoja ligą ir skiria gydymą per 1 dieną.
Kai kuriais atvejais galutinei diagnozei patvirtinti reikia ištyrimo, kuris gali užtrukti ilgiau nei vieną dieną. Apie tokius atvejus jus informuos gydytojas arba tyrimą atliekantis medicinos personalas.
Šeimos medicinos centre (Laisvės pr.10A) teikiamos paslaugos:
- Šeimos gydytojo konsultacijos
- Akušerio-gnekologo konsultacijos
- Laboratoriniai tyrimai
- Echoskopijos tyrimai
Šeimos medicinos centras laukia Jūsų darbo dienomis nuo 08:00 iki 20:00 valandos, adresu: Laisvės pr. 10A, Vilnius.
Laboratorinius tyrimus kviečiame atlikti:
- Grybo g.32A, Vilnius (teikiamos visos Centro paslaugos).
- Laisvės pr.10A, Vilnius (Business Garden verslo centre, B korpusas).